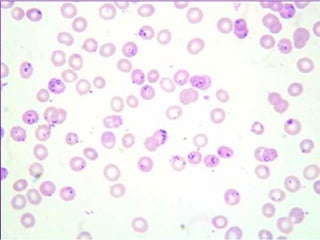

Este documento resume la malaria, una enfermedad parasitaria causada por Plasmodium y transmitida por mosquitos Anopheles. Explica el ciclo de vida del parásito, los síntomas como fiebre y anemia, el diagnóstico mediante exámenes de sangre, y el tratamiento con medicamentos como la quinina y la artemisinina. También cubre las complicaciones graves como la malaria cerebral, la epidemiología en Perú, y las medidas de prevención como los repelentes e insecticidas.